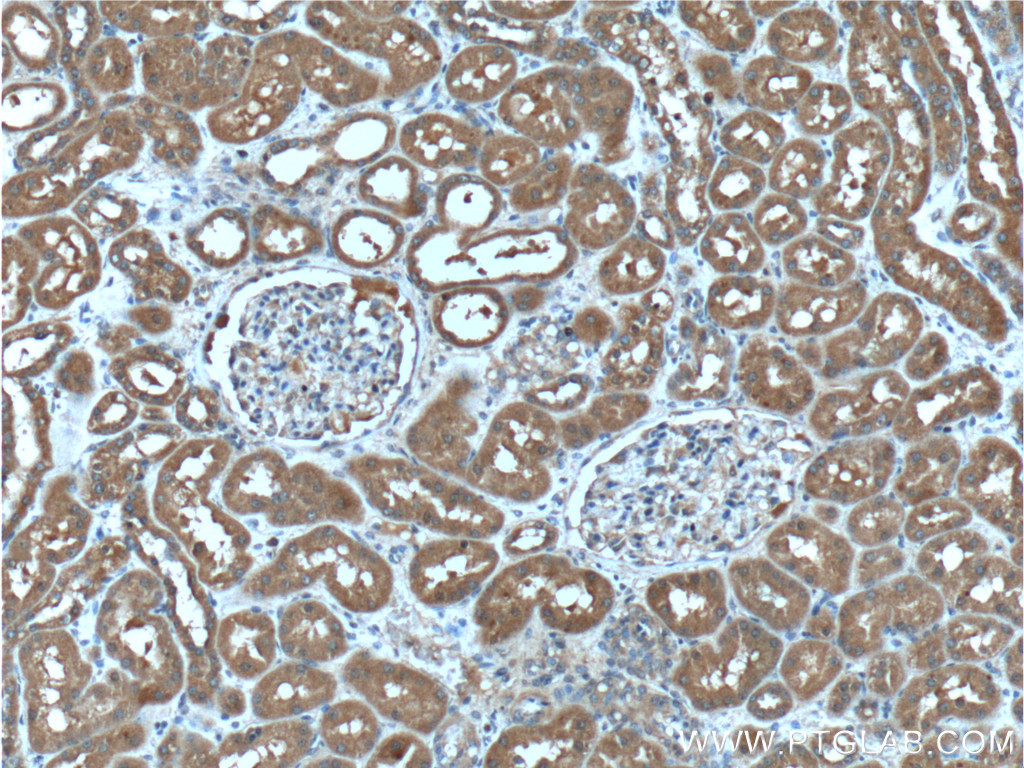

验证数据展示
产品信息
66284-1-PBS targets SDCCAG8 in WB, IHC, Indirect ELISA applications and shows reactivity with human samples.
| 经测试应用 | WB, IHC, Indirect ELISA Application Description |
| 经测试反应性 | human |
| 免疫原 |
CatNo: Ag4264 Product name: Recombinant human SDCCAG8 protein Source: e coli.-derived, PGEX-4T Tag: GST Domain: 1-360 aa of BC032454 Sequence: MAKSPENSTLEEILGQYQRSLREHASRSIHQLTCALKEGDVTIGEDAPNLSFSTSVGNEDARTAWPELQQSHAVNQLKDLLRQQADKESEVSPSRRRKMSPLRSLEHEETNMPTMHDLVHTINDQSQYIHHLEAEVKFCKEELSGMKNKIQVVVLENEGLQQQLKSQRQEETLREQTLLDASGNMHNSWITTGEDSGVGETSKRPFSHDNADFGKAASAGEQLELEKLKLTYEEKCEIEESQLKFLRNDLAEYQRTCEDLKEQLKHKEFLLAANTCNRVGGLCLKCAQHEAVLSQTHTNVHMQTIERLVKERDDLMSALVSVRSSLADTQQREASAYEQVKQVLQISEEANFEKTKHPSQ 种属同源性预测 |
| 宿主/亚型 | Mouse / IgG2b |
| 抗体类别 | Monoclonal |
| 产品类型 | Antibody |
| 全称 | serologically defined colon cancer antigen 8 |
| 别名 | Antigen NY CO 8, BBS16, CCCAP, hCCCAP, HSPC085, NY CO 8, SDCCAG8 |
| 计算分子量 | 713 aa, 83 kDa |
| 观测分子量 | 83 kDa |
| GenBank蛋白编号 | BC032454 |
| 基因名称 | SDCCAG8 |
| Gene ID (NCBI) | 10806 |
| RRID | AB_2881667 |
| 偶联类型 | Unconjugated |
| 形式 | Liquid |
| 纯化方式 | Protein A purification |
| UNIPROT ID | Q86SQ7 |
| 储存缓冲液 | PBS only, pH 7.3. |
| 储存条件 | Store at -80°C. The product is shipped with ice packs. Upon receipt, store it immediately at -80°C |
背景介绍
SDCCAG8, also named as CCCAP and NY-CO-8, plays a role in the establishment of cell polarity and epithelial lumen formation. It may play a role in ciliogenesis. Loss of SDCCAG8 function as a cause of a retinal-renal ciliopathy and validates exome capture analysis for broadly heterogeneous single-gene disorders. SDCCAG8 is localized at both centrioles and interacts directly with OFD1 (oral-facial-digital syndrome 1), which is associated with NPHP-RC.